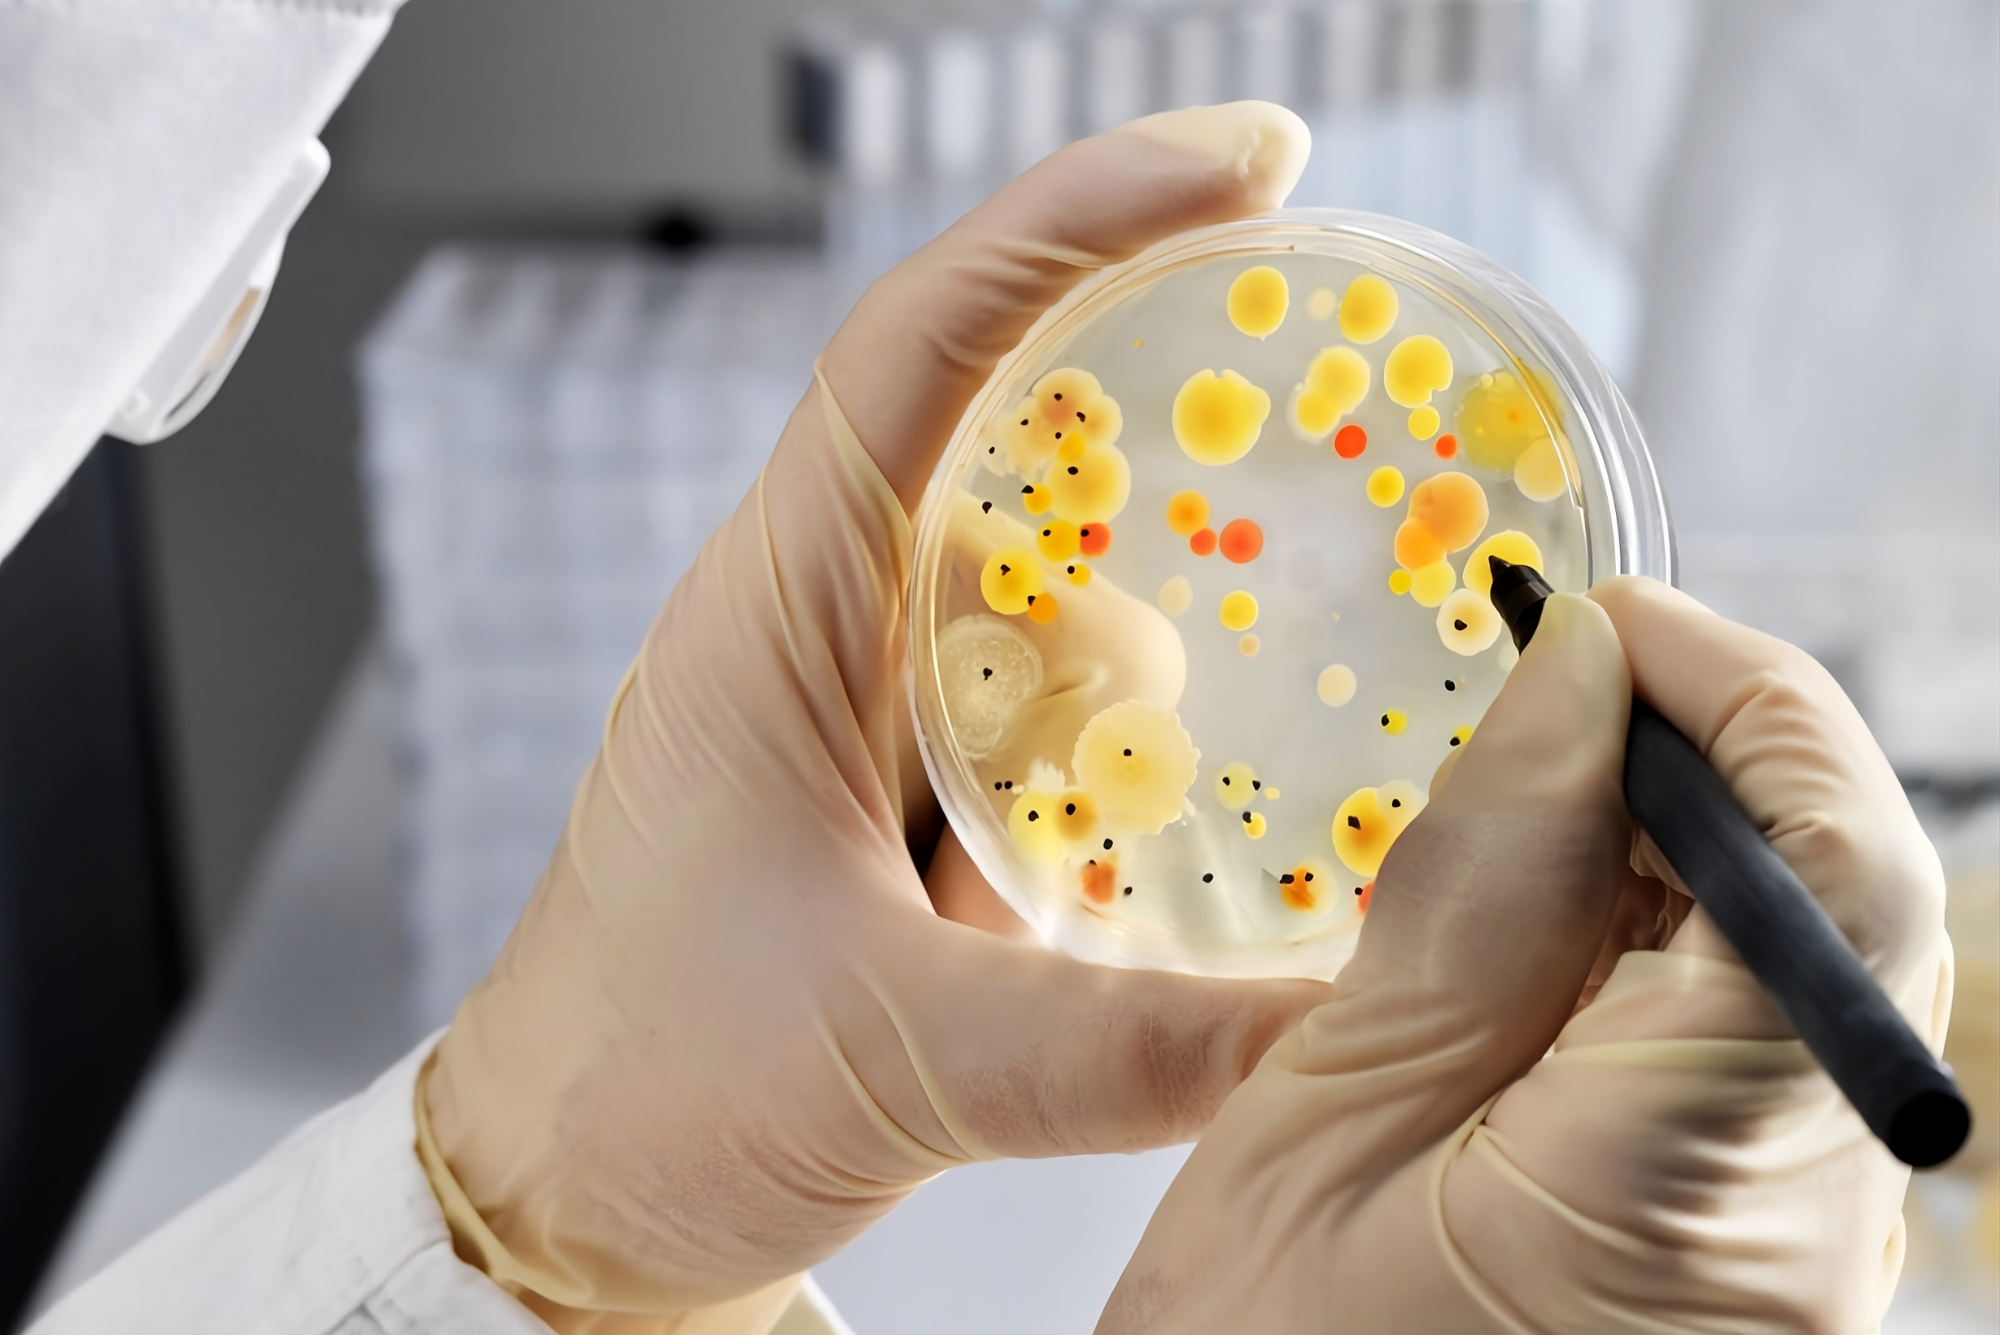

In-House Growth Promotion Testing: Why a Supplier’s Certificate of Analysis is Not Enough
Written By: AnalytiChem |
Why your lab's conditions are the final check on media performance.
In this article, you'll learn:
-
Why a supplier’s Certificate of Analysis (CoA) doesn’t satisfy regulatory requirements for end-user media verification
-
What pharmacopeial standards, EU GMP Annex 1, and US FDA cGMP regulations, specifically require of end-user laboratories
-
How transport, storage, and lab-specific variables can affect media performance after batch release
-
Why Growth Promotion Testing (GPT) functions as a system suitability check for a complete microbiological method
-
How in-house GPT supports Contamination Control Strategy (CCS) and environmental monitoring programs
The role of media manufacturers: ensuring batch quality
Microbiology prepared media manufacturers operate under strict quality management systems designed to ensure consistency and reproducibility. Before release, each batch of prepared culture media undergoes a series of quality control checks designed to verify microbiological performance, as well as key physical and chemical characteristics.
- Sterility testing ensures the media is free from contamination.
- pH verification confirms that the chemical environment is suitable for microbial growth.
- GPT with defined reference strains demonstrates that the medium can reliably support microbial proliferation.
- Physical inspections confirm visual and physical integrity.
- Stability studies validate that the product maintains its performance characteristics throughout the defined shelf life.
This comprehensive quality control framework aligns with internationally recognized standards for culture media quality control, such as ISO 11133, which defines preparation, production, storage, and performance testing requirements for microbiological culture media used in laboratories. This means laboratories receive culture media manufactured and tested under controlled conditions, supported by a Certificate of Analysis.
But despite these assurances, regulatory expectations require laboratories to confirm that media performs as expected under the specific conditions of their own testing environment.
Regulatory frameworks require media verification by the end user
Multiple global regulatory frameworks require that prepared microbiology media products be verified under the conditions in which they’re used. Relevant microbiological guidance is provided in pharmacopeial chapters including:
- USP Microbial Enumeration Tests
- USP Tests for Specified Microorganisms
- USP Sterility Tests
- European Pharmacopoeia Microbiological Examination of Non-Sterile Products
- European Pharmacopoeia Sterility
Across these pharmacopeial standards, laboratories must demonstrate that the culture media used in testing is capable of supporting microbial recovery under the conditions of the test, through growth promotion or media suitability testing. Growth promotion testing procedures and acceptance criteria are described in pharmacopeial guidance including USP <1117> Microbiological Best Laboratory Practices.
This is typically verified through GPT using defined reference microorganisms at low inoculum levels (typically 10-100 CFU) to confirm that the media can reliably support growth, and allow detection of microorganisms when present. GPT typically involves challenging the medium with defined microorganisms and incubating under conditions appropriate for recovery of bacteria, yeasts, or molds, depending on the intended application of the medium.
USP chapters are recognized as official compendial standards by the Food and Drug Administration (FDA). Under current Good Manufacturing Practice (cGMP) regulations (21 CFR Part 211), laboratory test methods and materials must be scientifically sound and appropriate for their intended use, and compendial methods are widely used to meet this expectation.
Are there additional requirements for sterile product manufacturing?
Sterile product manufacturing introduces further responsibilities for lab verification.
The revised EU GMP Annex 1—governing the manufacture of sterile medicinal products—specifies that culture media used for environmental monitoring and microbiological testing should undergo appropriate quality control, including growth promotion testing performed in accordance with pharmacopeial methods.
In the USA, the FDA’s Guidance for Industry on Sterile Drug Products Produced by Aseptic Processing (2004) sets equivalent expectations, requiring that culture media used in environmental monitoring and sterility testing demonstrate their ability to support growth of the microorganisms they are intended to detect.
Both frameworks converge on the same operational requirement: the end-user laboratory must verify that the media is fit for purpose, not simply accept a supplier’s batch release data.
EU GMP Annex 1 expects growth promotion testing to demonstrate that culture media can recover microorganisms relevant to the manufacturing environment. In addition to compendial reference strains, facilities should consider the inclusion of representative environmental isolates where appropriate to confirm detection capability. Reliance solely on supplier testing requires documented justification under both frameworks. These requirements reflect the principle that microbiological methods must be validated within the environment in which they will be used.
Why is end-user GPT necessary?
Even when media manufacturers perform rigorous quality testing, several factors can affect the performance of prepared media and compromise microbial recovery after the point of release. These include:
- Temperature fluctuations outside defined parameters
- Transport and storage conditions
- Extended storage periods
By performing in-house GPT, laboratories confirm that the media maintains its intended performance characteristics after delivery and storage. Lab-specific testing conditions provide further justification for this verification.
Differences in inoculum preparation, dilution techniques, incubation temperatures, durations, or plating methods can all affect microbial recovery. Testing the media within the lab’s own operational environment and procedures ensures compatibility and supports reliable results.
When media performance is compromised by any of these variables, the risk is not an obvious test failure, but a false negative—a result indicating absence of microbial contamination when contamination is, in fact, present.
In sterile product manufacturing and environmental monitoring, a false negative represents a significant microbiological risk because contamination may remain undetected, with potential implications for both patient safety and regulatory standing.
GPT as a method suitability check: method, media, and environmental isolates
Detection of environmental isolates is a particular consideration in sterile manufacturing facilities. Including representative environmental isolates in growth promotion or media suitability testing can help confirm that environmental monitoring programs are capable of detecting the microorganisms most likely to challenge aseptic processes.
GPT functions as a method suitability or performance verification check, confirming that the culture media, inoculum preparation, incubation conditions, and laboratory technique collectively support reliable microbial recovery, ensuring that sterility testing and environmental monitoring results are valid.
Supplier testing provides essential assurance of batch consistency, compliance with pharmacopeial specifications, and sterility at the point of release—but end-user GPT verifies that these attributes are maintained under the specific conditions of the receiving laboratory, and that the complete method is compatible with the media in use. This dual-layer approach is what gives microbiological results their defensible foundation.
GPT: an essential component of a robust Contamination Control Strategy
Growth Promotion Testing is integral to a comprehensive Contamination Control Strategy. GPT ensures that microbiological methods maintain their ability to detect contamination events, environmental monitoring results are accurate, and sterility testing remains reliable.
By identifying potential issues early, GPT contributes to proactive quality control, and supports regulatory expectations for maintaining control over sterile manufacturing environments.
AnalytiChem supports pharmaceutical and biotech companies with Redipor® prepared media—including tailor-made formulations that meet the unique requirements of specific environments—high-quality environmental monitoring solutions, and technical expertise aligned with current regulatory expectations.
If you're reviewing your environmental monitoring program or considering switching to a new supplier of prepared media, contact our team to assess potential gaps, strengthen compliance alignment, and ensure your production environment remains demonstrably under control.
FAQ: In-house GPT, Contamination Control Strategy, and Certificates of Analysis
Is in-house GPT expected by regulatory frameworks if my media supplier provides a Certificate of Analysis?
Which microorganisms must be used for GPT in a sterile manufacturing environment?
Does GPT verify the media or the method?
Can reliance on supplier GPT results be justified under Annex 1 or FDA cGMP regulations?
How does GPT support a Contamination Control Strategy?



